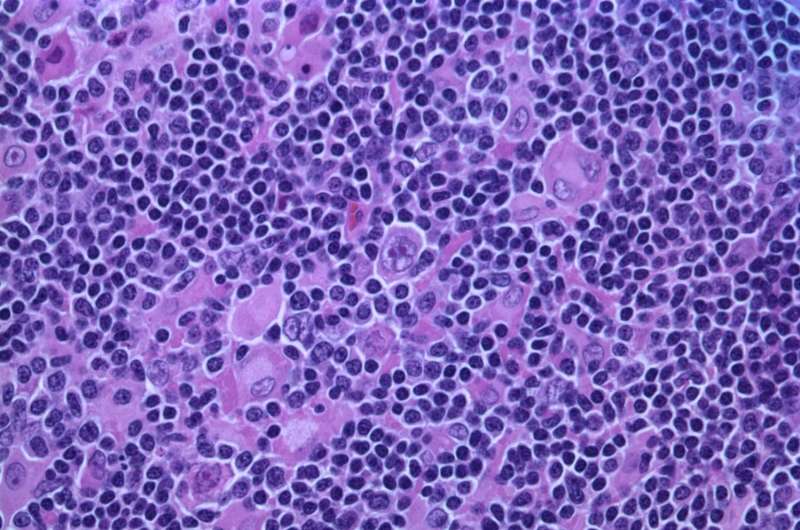

Известно, что раковые клетки пробуждают эмбриональные гены для роста. Новое исследование показывает, что болезнь также воздействует на белки, или «редакторы», которые контролируют считывание этих генов.
Результаты, опубликованные в журнале Nucleic Acids Research, помогают объяснить, почему опухоли растут так быстро и так хорошо адаптируются, и могут указать путь к новым методам лечения.
Эмбриональные клетки должны расти быстро и быть способны трансформироваться во множество различных типов тканей. Клетки полагаются на генетические программы, которые в конечном итоге отключаются по мере созревания тканей. Рак пробуждает эти программы, придавая заболеванию эмбриональный потенциал для роста.
Исследователи из Центра геномной регуляции (CRG) теперь показывают, что раковые клетки также изменяют инструменты редактирования клеток, чтобы стать похожими на эмбрионы. Это факторы сплайсинга, белки, которые редактируют РНК после того, как она была скопирована с ДНК, перестраивая различные сегменты в последовательности таким образом, чтобы изменить сообщение гена.
Обычно факторы сплайсинга помогают клеткам адаптироваться к изменяющимся условиям, обеспечивая возможность создавать различные белки из одного и того же гена. Исследование показало, что раковые клетки включают факторы сплайсинга, которые обычно активны только на ранних стадиях развития, помогая стимулировать рост опухоли.
«Мы обнаружили, что рак не изобретает совершенно новых трюков», — говорит доктор Микель Англада-Джиротто, ведущий автор исследования в Центре геномной регуляции. «Вместо этого он повторно использует старые программы, которые клетки обычно используют на ранних стадиях развития, когда необходим быстрый рост».
Исследователи описывают, как рак захватывает контроль над генными редакторами клетки. Когда активируются факторы, вызывающие рак, в частности печально известный онкоген MYC, баланс факторов сплайсинга нарушается. Сеть настолько тесно взаимосвязана, что нарушение работы только одной ее части вызывает волновой эффект во всей системе.
Когда активируется MYC или другой путь роста, инициирующий рак, это изменяет поведение нескольких «инициаторов» роста, вызывая цепную реакцию, которая включает факторы сплайсинга, которые стимулируют рост клеток, одновременно подавляя защитные факторы, которые обычно сдерживают рост.
«В сочетании с другими дефектами, которые накапливаются в клетке, эта полная перестройка факторов сплайсинга смещает баланс между здоровым ростом и переводом всей системы в режим борьбы с раком», — объясняет доктор Англада-Джиротто.
Исследование помогает объяснить, почему рак является таким опасным заболеванием. Это также открывает новые возможности. Если врачи смогут определить, когда факторы сплайсинга начинают меняться, они смогут выявлять рак раньше. И если лекарства смогут воздействовать только на один фактор сплайсинга, это может распространиться по всей сети и замедлить или остановить рост опухоли.
Открытие стало возможным благодаря тому, что исследователи обучили модель искусственного интеллекта считывать общую картину активности генов в клетках и делать выводы о том, что делают факторы сплайсинга за кулисами. Раньше ученым приходилось считывать каждую крошечную правку в каждой молекуле РНК, что было трудоемким и дорогостоящим процессом.
Авторы исследования полагают, что с помощью нового инструмента исследователи теперь могут сканировать тысячи существующих наборов данных, чтобы увидеть, как ведут себя факторы сплайсинга, помогая выявить, как рак захватывает контроль над клеткой, и выявляя скрытые слабые места.
Работой руководил доктор Англада Джиротто, а руководили профессор-исследователь ICREA Луис Серрано из Центра геномной регуляции и доктор Самуэль Миравет Верде из ETH Zurich.
Дополнительная информация: Исследование нуклеиновых кислот (2025). DOI: 10.1093/nar/gkaf855
Информация о журнале: Исследование нуклеиновых кислот